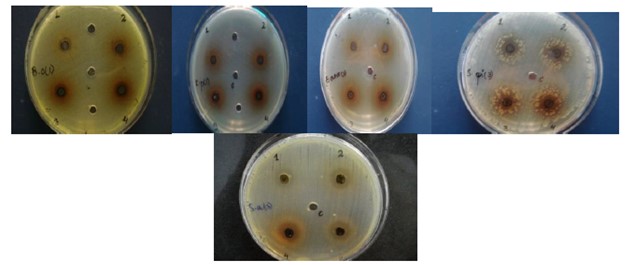
Bacteria showing zones of inhibition by ethanol extract

![]()
Vol. 2 No. 4 (2021): Volume 2 Issue 4
Research Article
-
In Vitro Antiviral Activity of AegleMarmelos against Influenza A (H1N1) Pdm09
Abstract views: 64Antibacterial Activity of AegleMarmelos against Fruit Extracts
Abstract views: 67Formulation and Evaluation of Loperamide HCl fast dissolving tablets using cross treated Xanthan Gum
Abstract views: 90Formulation and Evaluation of ethyl cellulose microspheres containing diclofenac sodium
Abstract views: 145Review Article